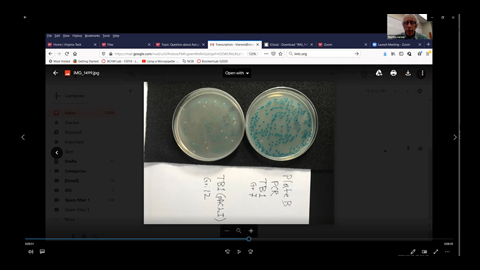

Contributors
Peter Kennelly

Articles by Peter Kennelly

Open Letters
An open letter to the ASBMB executive director search committee
Sept. 19, 2023
"As you sift through the applications ... look for signs of altruism, vision and an investment mentality rather than the extent of administrative experience and managerial acumen," Pete Kennelly writes.
Professional Development
What would Julia Child do?
Oct. 15, 2020
Pete Kennelly proposes that online labs should be designed with an eye to enhancing student participation and maintaining causal connections.

Education
Accreditation: Participant perspectives, in triplicate
Feb. 1, 2019
Representatives of three diverse institutions explain what ASBMB accreditation in biochemistry and molecular biology has brought to their programs.

How-to
The 10 commandments of grantsmanship
Jan. 1, 2019
Peter Kennelly offers his top-10 grant-writing guidelines in a biblical format.

Professional Development
Chasing unicorns
Nov. 1, 2018
As funding agencies work to quantify the productivity of researchers, Peter Kennelly proposes giving professors a percentage of credit for papers written by their students and trainees.

Education
STEM-focused gap years
Aug. 1, 2016
We wondered how stepping off the road of higher education influenced people's careers and outlook on life. Find out what our essayists had to say.

Professional Development
15 tips for effective interviewing
April 1, 2013
Peter J. Kennelly provides tips for knocking that job interview out of the park.

Education
Things to look for in a thesis adviser
Jan. 1, 2013
Here are some questions to ask yourself as you find your way in the first year of graduate school.

Education
Look at an exam, see a job application
Nov. 1, 2012
Students are becoming experts at negotiating for a few more points when their answers on assignments are close but no cigar. Peter J. Kennelly says teachers who allow themselves to manipulated this way are doing their students a disservice.

Education
Stranger in a strange land
Feb. 1, 2012
Peter J. Kennelly has advice for those who advise undergraduates.

Professional Development
Advice for new assistant professors
Dec. 1, 2011
Peter Kennelly offers a list of twelve suggestions that assistant professors should consider.

Professional Development
Peering below the surface
July 1, 2011
The letter of evaluation offers your first, and sometimes only, view of a job applicant as a whole person. Here are some tips from Pete Kennelly on making the best use an applicant's letters.